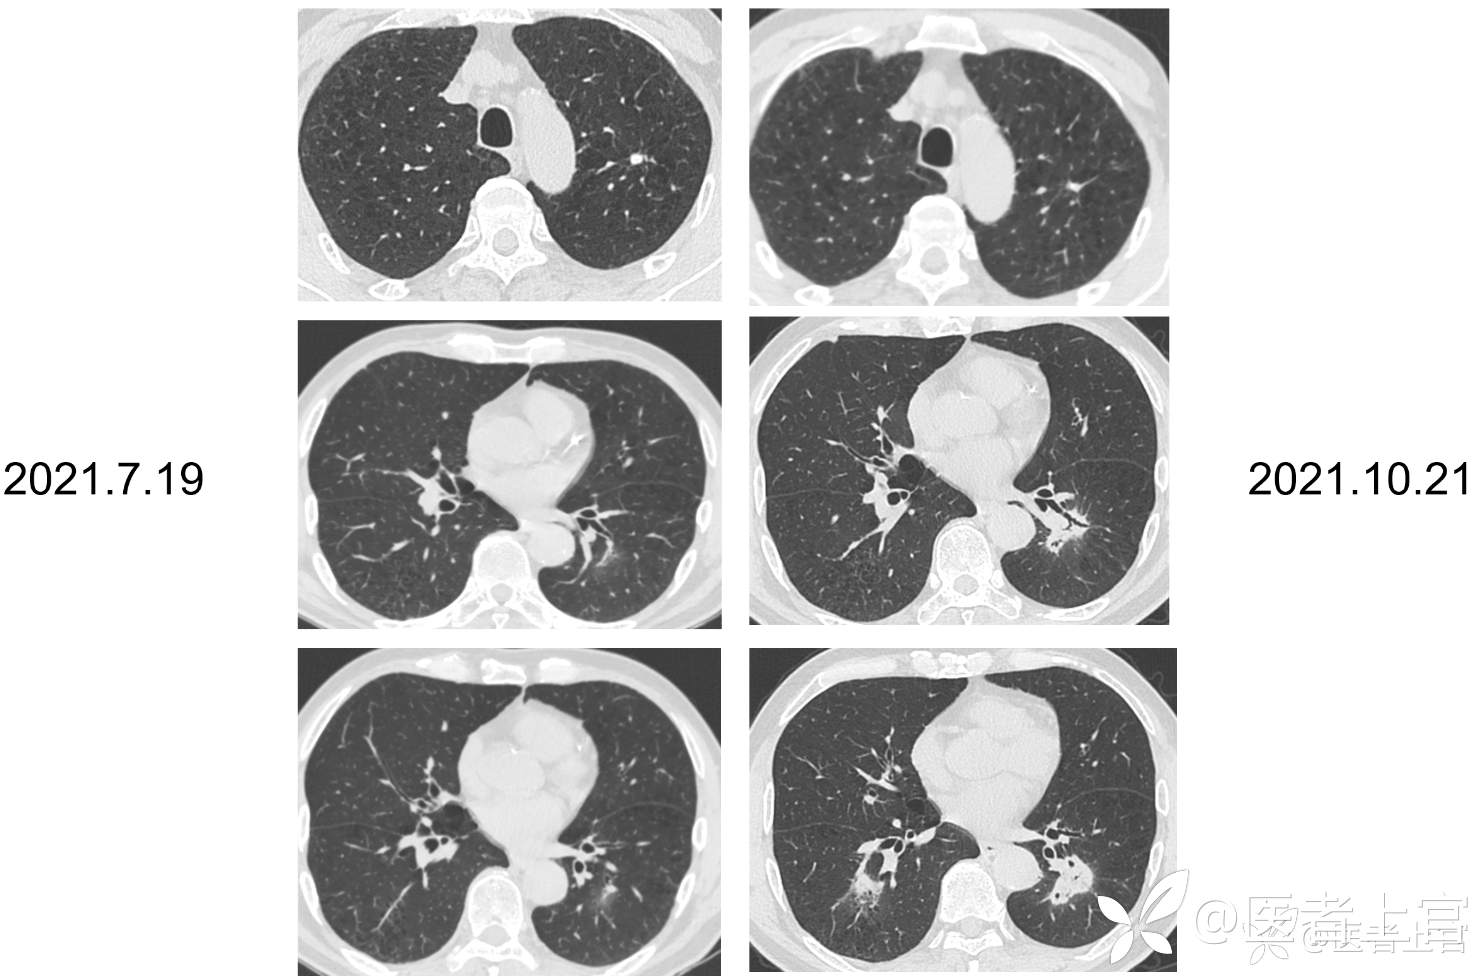
img

蹊跷的肺部阴影(2024年1月上海市疑难病例讨论)
病例介绍
患者,男,68岁;
主诉: 发现肺部阴影半年
现病史:患者半年前体检时行肺部CT示两下肺斑片模糊影,两肺局限性肺气肿及散在炎症,无咳嗽咳痰、胸闷气促、发热等不适,外院予以抗感染治疗(具体不详)。期间患者无胸闷气促,无咳嗽咳痰等不适,3月后患者于我院复查肺部CT示:两下肺模糊实变灶较前加重,两肺局限性肺气肿。门诊完善血指标示:C-反应蛋白 <0.50mg/L,白细胞计数 7.93x10^9/L↓,嗜中性粒细胞百分比 64%,淋巴细胞百分比 24.7%,血红蛋白 121g/L,血沉:5mm/h,肿瘤指标示: CYFRA(21-1) 4.25 ↑,鳞癌抗原 3.37 ↑,GM试验(-),隐球菌乳胶凝集试验阴性,真菌(1-3)-β-D葡聚糖 <37.5 ,考虑肺部感染予以口服左氧氟沙星(0.5g*5天)抗感染,拟进一步诊治收入我院。患者自起病以来,精神可,胃纳可,大便如常,小便如常,睡眠尚可,饮食未见异常,体重无明显变化。
既往史:高血压20余年,平日以硝苯地平1#bid+奥美沙坦酯1#bid控制血压,自述血压控制于150/80mmHg左右。痛风史,非布司他1#qod服用。陈旧性肺结核病史,曾正规抗结核治疗半年。否认其他传染病史,预防接种史按规定。胆囊切除术后,否认输血史。否认药物过敏史,否认食物过敏史。
个人史:吸烟50年,20支/天 ,无有毒有害物质接触史
婚育史:已婚已育。
家族史:家族中否认类似患者,否认家族性遗传病病史。
体格检查:T 36.2℃,P 82次/分, R 19次/分 ,BP 112/83mmHg,SpO2 99%(未吸氧);全身皮肤及黏膜无黄染,全身浅表淋巴结未触及肿大。胸廓正常,呼吸节律正常,双侧呼吸运动对称,语颤对称,无摩擦音,双肺呼吸音低,未及干湿啰音,未及哮鸣音,余阴性。
辅助检查:
【7.19肺CT】两下肺斑片模糊影,渗出可能,建议抗炎后复查。两肺局限性肺气肿;左肺上叶及右肺下叶背段纤维、结节状钙化灶伴右肺下叶局部支气管牵拉扩张
【10.21肺CT】两下肺模糊实变灶,较前片(2021-7-19)进展,首先考虑炎症,建议抗炎治疗后短期复查。两肺局限性肺气肿;左肺上叶及右肺下叶背段纤维、结节状钙化灶伴右肺下叶局部支气管牵拉扩张。主动脉、冠脉硬化。
入院诊断:肺部阴影,肺炎,高血压,痛风
入院后检验:
感染相关
【C反应蛋白+全血细胞分析(CBC)】:C-反应蛋白 0.78mg/L,白细胞计数 6.94×10^9/L,嗜中性粒细胞百分比 68.2%,淋巴细胞百分比 18.2%↓,单核细胞百分比 7.5%,嗜酸性粒细胞百分比 5.8%,嗜碱性粒细胞百分比 0.3%,血红蛋白 133g/L,血小板计数 206x10^9/L,
【血气血糖分析组合(未吸氧)】:PH 7.431,二氧化碳分压 38.7mmHg,氧分压 92.7mmHg,氧饱和度 97.9%,乳酸(全血) 1.2mmol/L,
【降钙素原测定】:降钙素原 0.11ng/ml ;
【红细胞沉降率】:红细胞沉降率ESR 4.00mm/h ;
【隐球菌乳胶凝集试验】:隐球菌乳胶凝集试验 阴性 ;
【真菌(1-3)-β-D葡聚糖】真菌(1-3)-β-D葡聚糖 <10.0pg/ml
【隐球菌乳胶凝集试验】:隐球菌乳胶凝集试验 阴性
【T-spot1】:结核分枝杆菌T细胞免疫反应 阳性↑,抗原刺激孔 9,阴性对照孔 0,阳性对照孔 ≥20 ;
【呼吸道病毒九联体检测】:嗜肺军团菌抗体IgM 阴性,肺炎支原体抗体IgM抗体 阴性,Q热立克次体抗体IgM 阴性,肺炎衣原体抗体IgM抗体 阴性,腺病毒抗体IgM 阴性,呼吸道合胞病毒-IgM抗体 阴性,甲型流感病毒抗体IgM 阴性,乙型流感病毒抗体IgM 阴性,副流感病毒1.2.3型抗体IgM 阴性 ;
【支气管肺曲霉病】:总IgE 36.7KU/L,烟曲霉m3sIgE 0.00KUA/L,霉菌混合mx2 0.02KUA/L ;
肿瘤相关:
【肿瘤指标】:鳞癌抗原(SCC) 1.00ng/ml ;癌胚抗原 0.550ng/mL,甲胎蛋白(AFP) 3.31ng/mL,糖类抗原(CA19-9) 4.66U/ml,糖类抗原(CA125) 5.09U/ml,糖类抗原(CA15-3) 5.59U/ml,糖类抗原72-4 0.96U/ml,细胞角蛋白19(Cyfra211) 5.16ng/ml↑,神经烯醇化酶(NSE) 9.24ng/ml,游离前列腺特异性抗原 0.215ng/ml,总前列腺特异性抗原 0.955ng/ml,proGRP 39.60pg/ml ; 糖类抗原CA50 2.07U/ml,糖类抗原242(V) 2.30U/ml
风湿免疫相关:
【类风关的相关检测分型+抗中性粒细胞抗体4项】:阴性,
【抗核抗体组合+抗心磷脂抗体】:阴性
常规生化
【出凝血系列检测】:正常
【糖化血红蛋白】:糖化血红蛋白-A1c 5.4%
【心梗标志物】:正常
【TB抗体】:结核抗体 阴性
【生化】:白蛋白 41.8g/L,丙氨酸氨基转移酶 17IU/L,天门冬氨酸氨基转移酶 20U/L,乳酸脱氢酶 186U/L,肌酐 87umol/L,eGFR-EPI Cr 78ml/min,肌酸激酶 75U/L ;
入院检查:
【7.19肺CT】两下肺斑片模糊影,渗出可能,建议抗炎后复查。两肺局限性肺气肿;左肺上叶及右肺下叶背段纤维、结节状钙化灶伴右肺下叶局部支气管牵拉扩张。主动脉、冠脉硬
【10.21肺CT】两下肺模糊实变灶,较前片(2021-7-19)进展,首先考虑炎症,建议抗炎治疗后短期复查。两肺局限性肺气肿;左肺上叶及右肺下叶背段纤维、结节状钙化灶伴右肺下叶局部支气管牵拉扩张。主动脉、冠脉硬化。

专科检查
【气管镜】声带:开闭良好气管:气管管腔通畅,软骨环清晰,粘膜光滑。隆突:锐利。左侧:各段支气管管腔通畅,粘膜光滑。右侧:右下叶背段见白色稍脓分泌物,管腔通畅。各段支气管管腔通畅,粘膜光滑。于右下叶前外后基底段灌洗,灌洗液送检细胞分类、NGS、Xpert、GM试验、细菌真菌培养,乳胶凝集试验。
灌洗液送检:
【BALF细胞分类】:中性粒细胞百分比 3%,淋巴细胞百分比 3%,嗜酸粒细胞百分比 0%,嗜碱粒细胞百分比 0%,巨噬细胞百分比 94%,分类不明细胞 0% ;
【Xpert结核分枝杆菌】:结核分枝杆菌 未检出,利福平耐药 未检出 ;
【真菌涂片检查+★真菌培养及鉴定(进口仪器)】:未生长
【细菌+嗜血杆菌培养鉴定】:未检出
【GM试验】:半乳甘露聚糖(GM试验) 0.37S/CO ;
【隐球菌乳胶凝集试验】:隐球菌乳胶凝集试验 阴性
【NGS】检出列表:人类β疱疹病毒7型,细环病毒,细环病毒16型;
【灌洗液病理】 “右下肺基底段肺泡灌洗液”未查及肿瘤细胞。
【11-03胸部平扫增强】 两下肺团片实变影伴内部充气支气管征,目前倾向首先考虑炎症,两肺局限性肺气肿;左肺上叶及右肺下叶背段纤维、结节状钙化灶伴右肺下叶局部支气管牵拉扩张;主动脉、冠脉硬化。


入院后治疗:予以左氧氟沙星氯化钠注射液静脉抗感染治疗,完善气管镜送检肺泡灌洗液未检出细菌真菌,经验性抗感染后肺内病灶未见吸收
讨论目的:患者肺部阴影原因及下一步诊断与治疗@影像丘 @影像涛 @爱影像 @影像宝 @唐绍宏 @李梦杰huxi @全景张教授 @belb咏歌 @程先进 @放射科医师宋医生
















































